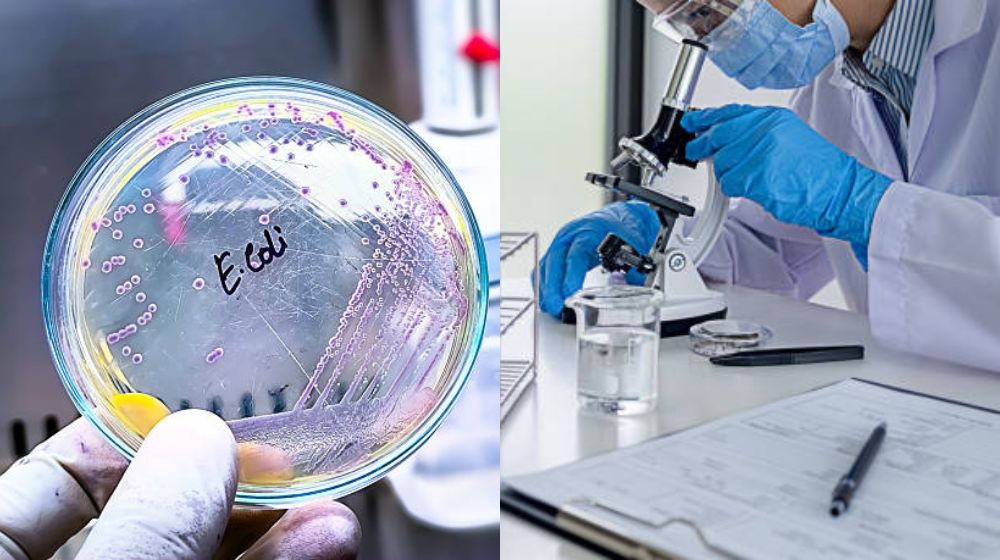
Nước sạch là gì - Thế nào là nước sạch chỉ tiêu đánh giá nước sạch

Nước sạch là gì? Thế nào là nước sạch hay nguồn nước sạch là gì? Là những câu hỏi được rất nhiều thợ kỹ thuật và người làm trong ngành nước đặt ra cho các kỹ sư đường ống của chúng tôi. Để tránh hiểu sai và có cách ứng dụng đúng, dưới đây là phần giải đáp rõ ràng nhất.
1. Nước sạch là gì? Thế nào là nước sạch
Nước sạch là loại nước đạt các tiêu chuẩn an toàn cho sức khỏe con người, được xử lý và kiểm soát chất lượng, có thể sử dụng cho mục đích sinh hoạt, sản xuất và các hoạt động đời sống. Khi tìm hiểu thế nào là nước sạch và nước sạch là gì, bạn sẽ thấy rằng nước sạch phải đảm bảo không gây rủi ro bệnh tật, không gây ô nhiễm và an toàn với môi trường.

Để xác định thế nào là nước sạch, nguồn nước sạch cần đáp ứng đồng thời các yêu cầu sau:
- Không chứa vi khuẩn, virus, ký sinh trùng gây bệnh
- Hàm lượng kim loại nặng, hoá chất, thuốc bảo vệ thực vật… nằm trong giới hạn an toàn
- Có màu trong, không mùi lạ, không vị bất thường
- Chỉ tiêu vật lý & hoá học ổn định theo tiêu chuẩn quy định

Như vậy, khi đặt câu hỏi nước sạch là gì, chúng ta hiểu rằng đó là nước đáp ứng cả yếu tố an toàn, cảm quan và tiêu chuẩn y tế.
2. Nguồn nước sạch là gì? Đến từ đâu
Để biết nguồn nước sạch là gì và đến từ đâu, cần hiểu rằng nguồn nước sạch có thể hình thành từ tự nhiên hoặc nhân tạo:
2.1 Trong tự nhiên nguồn nước sạch là gì
Nguồn nước sạch trong tự nhiên là những dòng nước được hình thành bởi quy luật địa chất và khí hậu, không qua xử lý công nghiệp nhưng vẫn giữ được độ trong, ít ô nhiễm và có thể khai thác. Chẳng hạn như:
- Nước ngầm từ các tầng chứa nước sâu, được đất đá lọc tự nhiên
- Suối đầu nguồn, băng tuyết tan ở khu vực ít hoạt động con người
- Nước mưa, nước đọng trên các tán lá,…

Tuy nhiên, khi tìm hiểu nguồn nước sạch là gì, cần lưu ý rằng không phải mọi nguồn nước sạch tự nhiên đều an toàn tuyệt đối vì vẫn có thể chứa vi khuẩn, hoá chất hoặc tạp chất
2.2 Thế nào là nước sạch nhân tạo
Thế nào là nước sạch nhân tạo? Đây là loại nước được con người thu gom, xử lý và kiểm soát chất lượng theo tiêu chuẩn vệ sinh. Các nguồn điển hình:
- Nước sạch đô thị, được xử lý tại nhà máy cấp nước rồi phân phối qua đường ống
- Nước từ sông, hồ được lọc, lắng, khử trùng thành nước sạch
- Nước sạch ngầm được khai thác và xử lý bằng hệ thống lọc, khử sắt, mangan, vi sinh
- Nước thải được xử lý lọc công nghệ cao để đạt chuẩn nước sạch (tái sử dụng)

Nhờ quy trình xử lý và giám sát định kỳ, nước sạch nhân tạo có chất lượng ổn định, kiểm soát được rủi ro ô nhiễm và phù hợp với tiêu chuẩn an toàn hiện hành.
3. Vai trò của nước sạch là gì trong đời sống con người
Khi bàn về nước sạch là gì, không thể bỏ qua vai trò của nó đối với cơ thể con người. Khoảng 75% trọng lượng cơ thể con người là nước, tham gia vào tuần hoàn, điều hòa thân nhiệt, tiêu hóa và bài tiết. Hiểu rõ thế nào là nước sạch giúp chúng ta đánh giá được tầm quan trọng của việc sử dụng nước đúng chuẩn.
- Duy trì sự sống và sức khỏe, hạn chế nguy cơ bệnh truyền qua nước
- Đảm bảo vệ sinh cá nhân và cộng đồng, góp phần phòng ngừa dịch bệnh
- Hỗ trợ sản xuất, công nghiệp và nông nghiệp, giữ ổn định chất lượng sản phẩm và an toàn lao động
- Phát triển kinh tế – xã hội, nâng cao chất lượng cuộc sống và dịch vụ đô thị

Nói cách khác, khi hiểu nước sạch là gì, chúng ta sẽ thấy đó là nền tảng cho phát triển bền vững và sức khỏe cộng đồng.
4. Chỉ tiêu đánh giá nguồn nước sạch là gì
Chỉ tiêu đánh giá nước sạch là hệ thống các chỉ số kỹ thuật dùng để xác định nước có an toàn cho sức khỏe và phù hợp cho mục đích sinh hoạt hay không. Các tiêu chuẩn này được xây dựng dựa trên nghiên cứu y tế, môi trường và quy định pháp luật. Những nhóm chỉ tiêu cốt lõi gồm:
- Chỉ tiêu vi sinh: Vi khuẩn, virus, E.coli, coliform tổng.
- Chỉ tiêu hóa học: Kim loại nặng (As, Pb, Hg), amoni, nitrat, clorua, thuốc bảo vệ thực vật…
- Chỉ tiêu vật lý: Độ đục, màu, mùi, vị, độ dẫn điện, nhiệt độ.
- Chỉ tiêu cảm quan và an toàn phóng xạ: Đảm bảo nước trong, không mùi lạ, không vượt mức phóng xạ tự nhiên
Tại Việt Nam, nước sạch sinh hoạt được đánh giá theo QCVN 01-1:2018/BYT, quy định giới hạn tối đa cho hơn 50 chỉ tiêu. Chỉ khi các giá trị đo nằm trong ngưỡng cho phép, nước mới được công nhận là nước sạch đạt chuẩn.
5. Tại sao nói nước sạch là thước đo cuộc sống
Nước sạch không chỉ là nhu cầu thiết yếu của con người mà còn phản ánh mức độ phát triển và chất lượng cuộc sống của một quốc gia. Lấy ví dụ:
- Các quốc gia phát triển như Nhật Bản, Singapore, Đức: Hầu hết người dân có tiếp cận 100% nước sạch, mạng lưới cấp nước hiện đại, kiểm soát chất lượng nghiêm ngặt. Kết quả là tỷ lệ bệnh liên quan đến nước thấp, sức khỏe cộng đồng ổn định, chất lượng cuộc sống cao
- Các quốc gia đang phát triển hoặc nghèo như Kenya, Ethiopia, Haiti: Nhiều khu vực người dân vẫn phải sử dụng nước chưa qua xử lý hoặc nguồn nước bị ô nhiễm, dẫn đến bệnh tiêu chảy, tả, viêm gan A… ảnh hưởng trực tiếp đến sức khỏe và năng suất lao động

Qua ví dụ này, nước sạch không chỉ là nhu cầu cơ bản mà còn là thước đo khả năng phát triển, mức sống và sức khỏe cộng đồng
6. Ứng dụng của nguồn nước sạch là gì
Nguồn nước sạch giữ vai trò thiết yếu trong mọi hoạt động sống và sản xuất của con người. Các ứng dụng tiêu biểu gồm:
- Phục vụ sinh hoạt hằng ngày như uống, nấu ăn, tắm rửa, vệ sinh,…
- Dùng trong y tế như khử trùng, vệ sinh dụng cụ và phòng bệnh
- Ứng dụng trong công nghiệp và chế biến thực phẩm để đảm bảo an toàn và chất lượng sản phẩm
- Tưới tiêu nông nghiệp và cung cấp nước cho chăn nuôi
- Sử dụng làm nguyên liệu trong sản xuất nước ngọt các loại và nhiều loại đồ uống đóng chai
- Bảo vệ môi trường và duy trì hệ sinh thái nước

7. Hậu quả của việc thiếu nguồn nước sạch là gì
Thiếu nước sạch ảnh hưởng trực tiếp đến sức khỏe con người, môi trường và phát triển kinh tế – xã hội. Một số hậu quả điển hình gồm:
- Nguy cơ bệnh tật tăng cao: nước bẩn hoặc ô nhiễm dễ gây tiêu chảy, tả, thương hàn, viêm gan A, các bệnh đường ruột và nhiễm khuẩn.
- Suy giảm sức khỏe cộng đồng: trẻ em và người già là nhóm dễ bị tổn thương, dẫn đến tỷ lệ tử vong và suy dinh dưỡng tăng
- Ảnh hưởng sinh hoạt và đời sống: thiếu nước sạch khiến việc nấu ăn, tắm rửa, giặt giũ trở nên khó khăn, giảm chất lượng cuộc sống
- Tác động tới môi trường: khai thác nước bẩn hoặc nguồn nước ô nhiễm làm suy thoái hệ sinh thái, gây mất cân bằng sinh thái
- Kìm hãm phát triển kinh tế – xã hội: thiếu nước sạch ảnh hưởng đến sản xuất nông nghiệp, công nghiệp, dịch vụ, làm giảm năng suất lao động và mức sống của cộng đồng

Nhìn chung, việc thiếu nước sạch không chỉ là vấn đề cá nhân mà còn là nguy cơ lớn đối với sức khỏe cộng đồng, môi trường và sự phát triển bền vững của xã hội.
8. Sản xuất nước sạch tại các nhà máy
Nước sạch được tạo ra qua một chuỗi xử lý liên tục nhằm loại bỏ tạp chất, vi sinh và các chất ô nhiễm. Ở từng bước trong hệ thống đường ống, thiết bị lọc và các loại van nước đều phối hợp để đảm bảo nguồn nước đầu ra đạt chuẩn an toàn. Dưới đây là một số bước chính trong quy trình sản xuất nước sạch trong nhà máy:
- Thu nước thô: Nước từ sông, hồ hoặc giếng khoan được hút qua rọ hút của bơm công suất lớn, là bước đầu tiên đưa nước thô vào hệ thống xử lý nước sạch.
- Lọc sơ bộ trên đường ống: Trước khi đi vào cụm xử lý, nước được dẫn qua Y lọc để loại bỏ các hạt cặn nhỏ, tạo điều kiện thuận lợi cho các bước xử lý nước sạch phía sau.
- Sử dụng keo tụ và tạo bông: Hóa chất được pha và đưa vào dòng nước để các hạt li ti kết dính lại thành bông cặn lớn, giúp nâng cao hiệu quả tạo nước sạch ở giai đoạn tiếp theo.
- Dẫn nước đến bể lắng: Dòng nước được đưa vào bể lắng để bông cặn chìm xuống đáy. Việc xả cặn theo chu kỳ giúp giữ ổn định chất lượng nước sạch trong toàn bộ quy trình.
- Lọc tinh: Nước tiếp tục đi qua các lớp vật liệu lọc như cát, sỏi và than hoạt tính nhằm loại bỏ tạp chất nhỏ, góp phần nâng cao độ trong và chất lượng nước sạch thành phẩm.
- Khử trùng, lưu trữ & phân phối: Nước được khử trùng bằng clo, ozone hoặc tia UV rồi dẫn về bể chứa. Từ đây, hệ thống van điều chỉnh và kiểm soát áp lực đảm bảo nước sạch được phân phối an toàn, liên tục đến người sử dụng

9. Các vấn đề liên quan đến nguồn nước sạch là gì
Khi tìm hiểu nguồn nước sạch là gì, chúng ta không chỉ xem xét cách hình thành và vai trò của nước mà còn phải đối mặt với những thách thức ngày càng nghiêm trọng. Các vấn đề này ảnh hưởng trực tiếp đến khả năng tiếp cận nước sạch, làm thay đổi cách chúng ta hiểu nước sạch là gì và thế nào là nước sạch trong bối cảnh hiện đại.
9.1 Xung đột xoay quanh nguồn nước sạch
Một trong những vấn đề nổi bật khi bàn về nguồn nước sạch là gì là nguy cơ xung đột giữa các quốc gia hoặc khu vực sử dụng chung nguồn nước. Tài nguyên nước ngày càng suy giảm khiến nhiều nước phải cạnh tranh quyền khai thác, dẫn đến:
- Xung đột liên quan đến các con sông xuyên biên giới
- Tranh chấp quyền kiểm soát hồ chứa và đập thủy điện
- Mất cân bằng tài nguyên giữa thượng nguồn và hạ nguồn

Trong bối cảnh này, khái niệm nước sạch là gì, thế nào là nước sạch không chỉ mang ý nghĩa sinh hoạt mà còn trở thành yếu tố chiến lược, thậm chí là “vũ khí mềm” trong quan hệ quốc tế
9.2 Ô nhiễm nguồn nước sạch
Một vấn đề khác ảnh hưởng trực tiếp đến nhận thức về nguồn nước sạch là gì là tình trạng ô nhiễm cả ở tự nhiên lẫn nguồn nước nhân tạo. Khi các tiêu chuẩn về nước sạch không còn được đảm bảo, ô nhiễm gây ra hàng loạt hệ quả:
- Nước bị nhiễm vi sinh, kim loại nặng, hóa chất độc hại
- Hoạt động công nghiệp, chăn nuôi, nông nghiệp làm suy giảm chất lượng nước
- Rác thải nhựa và hóa chất tồn dư phá hủy hệ sinh thái nước


